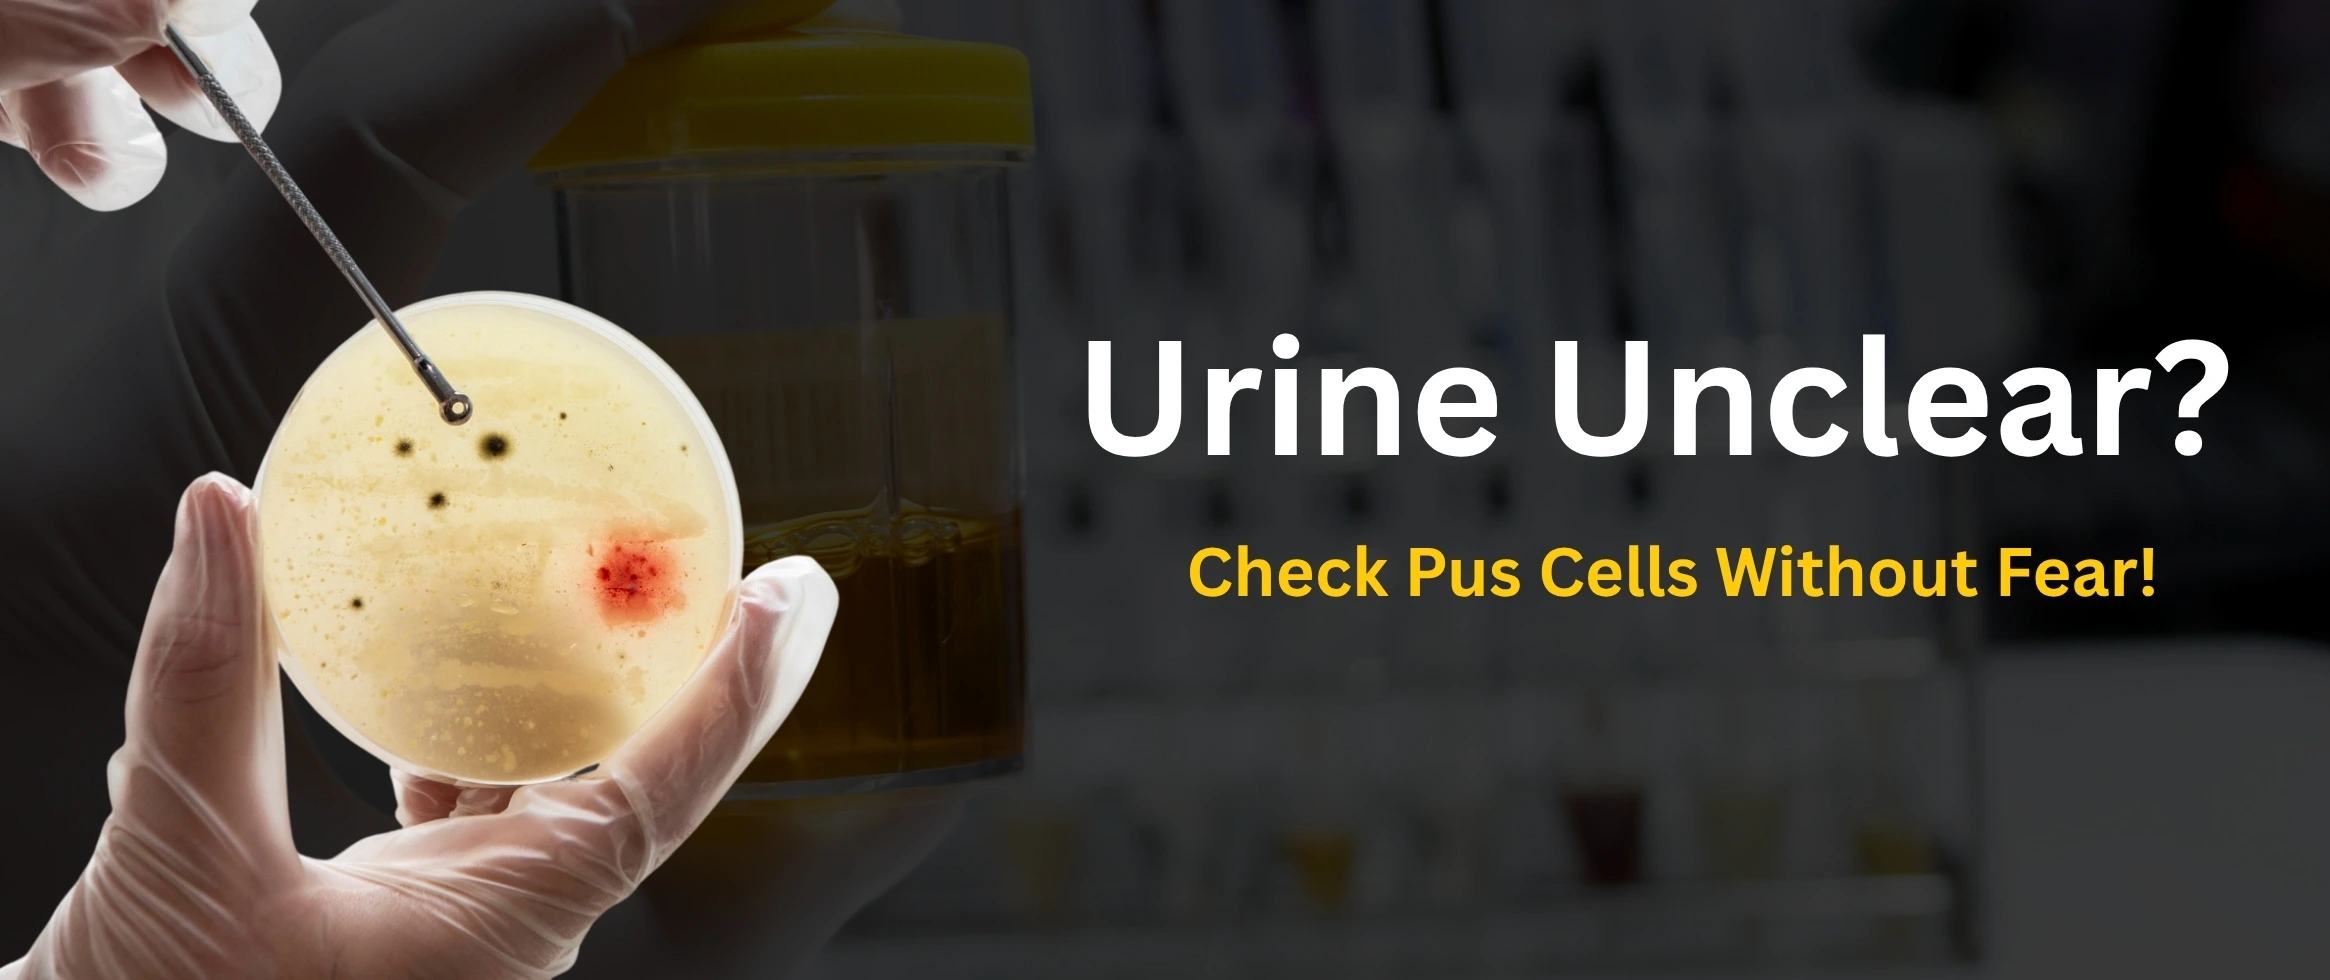

Chloride, Urine

Gender for Male, Female
No special preparation required

Sample Type
Urine
 NABL approved
NABL approved Labs
 Most Trusted by
Most Trusted by Doctors
 Accuracy &
Accuracy & timely reporting
 Widest Range
Widest Range of Tests